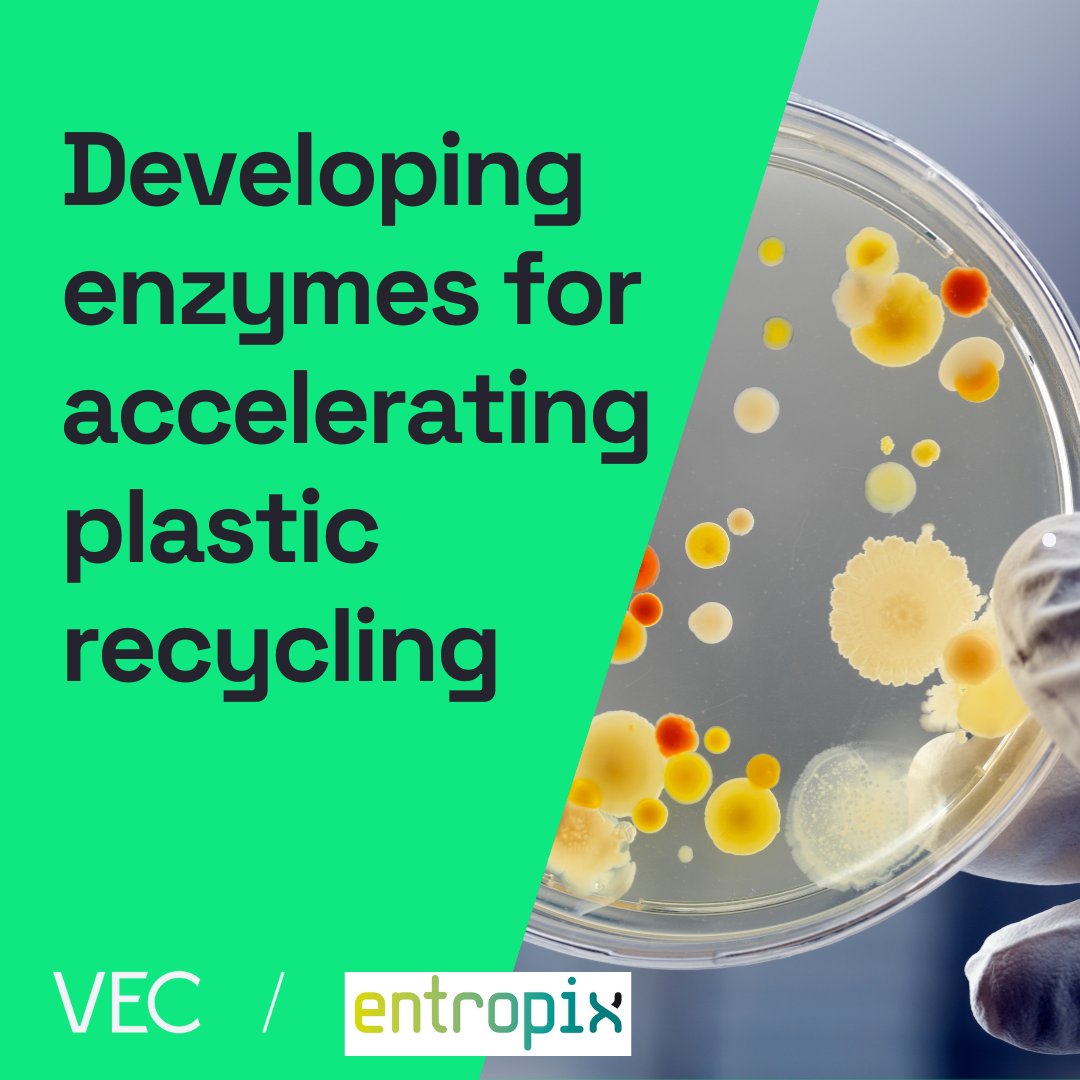
VEC tweet media

Sabitlenmiş Tweet
Digital Innovation Facility
173 posts

Digital Innovation Facility
@DIF_Liverpool
Applying new research and methodologies with the aim of transforming digital innovation
Dover Street,Liverpool Katılım Mayıs 2022
133 Takip Edilen162 Takipçiler
Digital Innovation Facility retweetledi
Digital Innovation Facility retweetledi

Huge congratulations to Professor Andy Levers (@DIF_Liverpool and @VEC_VE) who has been awarded an OBE for services to industry and the economy in the 2025 New Year Honours list 🎉
Find out more: news.liverpool.ac.uk/2024/12/30/pro…

English
Digital Innovation Facility retweetledi

Want a backstage pass to our #MixedReality lab at @DIF_Liverpool? Now you can immerse yourself and explore our facilities by clicking the buttons to see how we utilise emerging tools for supporting businesses across sectors...
Check it out: tinyurl.com/2runda2f

English
Digital Innovation Facility retweetledi

🎙️ The @VEC_VE teams supported Musicseen in adopting #AI for enhancing their data collection and analysis processes, improving their service to customers by offering the very latest in local music!🎼
Full case study here: tinyurl.com/2cwk8h9w

English
Digital Innovation Facility retweetledi

Digital experts at the @VEC_VE have worked with Image Surveys Ltd to explore #drone solutions for 3D model reconstruction, thermal image analysis and data integration, expanding their product line and improving competitiveness!
Read more here: shorturl.at/6KQfK

English

Some of our recent projects include:
🧫 Streamlining enzyme testing
🏥 Digital twins for enhanced learning
🦠 Analysing perception data of COVID-19
👭 Meta humans for advanced storytelling
🦮 Digital dogs for improved safety
Click here for more ➡️ shorturl.at/LSe1p

English
Digital Innovation Facility retweetledi
Digital Innovation Facility retweetledi

The VEC introduced emerging tech to Entropix Ltd, such as #computervision to automate manual processes and improve accuracy of data collection. #Machinelearning methods can support in the analysis of DNA sequences for accelerating #enzyme development
📽️tinyurl.com/449hvu3c

English
Digital Innovation Facility retweetledi

NEWS | Our @livunigeog & @DIF_Liverpool researchers are partners in a new hi-tech collaboration with South Korea that aims to improve bus journey times and connectivity in @LpoolCityRegion
Find out more➡️bit.ly/4cVvu3i

English

Policy makers, partners and stakeholders from the media and academia attended the launch of the Digital Media & Society Institute (DMSI) last week at the @DIF_Liverpool, hearing insights into the key areas of focus for the institute.
Read more here: tinyurl.com/say9bzm2

English
Digital Innovation Facility retweetledi

Exciting morning last week as our engineers participated in a #drone capture session, using two drones equipped with #photogrammetry and thermal scanners, capturing University of Liverpool's Digital Innovation Facility.


English
Digital Innovation Facility retweetledi

Great to visit @DIF_Liverpool with Unilever partners to see how new digital tech being used by the city and industry @LivUniResearch @livunibusiness

English
Digital Innovation Facility retweetledi

LCR’s first Innovation Investment Week to highlight huge opportunities, while inspiring future innovators.
Events include @LivUni's Pint of Science and exclusive talks with innovative researchers and academics at the @MIF_UoL
Find out more here: kqliverpool.co.uk/7101-2/

English
Digital Innovation Facility retweetledi

👩💻 Tour of the Digital Innovation Facility
In-person tour of @DIF_Liverpool, state-of-the-art lab space for robotics, AI, modelling & simulation, immersive technologies and data analytics.
@LivResearcher #UniLivImpact24
🔹 Register here: liverpool.ac.uk/researcher/mak…

English
Digital Innovation Facility retweetledi

@DefProcEng engaged with Horizons to explore how best to expand their existing #3DPrinting capabilities beyond prototypes for small batch production, adopting advanced materials and developing in-house skills.
tinyurl.com/mup8hbtd


English
Digital Innovation Facility retweetledi

🌍💚EARTH DAY 2024💚🌍
The VEC has recently collaborated with scientists at Entropix to develop #enzymes to accelerate the recycling of plastics, protecting our planet
#EarthDay #PeopleVSPlastic
Read more here: tinyurl.com/52b5f9tn

English
Digital Innovation Facility retweetledi

The VEC had a great morning at @DIF_Liverpool, welcoming guests from @DogsTrust to explore first-hand and interact with the latest 'virtual dog' we have been developing.

English
Digital Innovation Facility retweetledi

Gain an insight into how digital media can effectively support research with this #UniLivImpact24 tour of the Digital Innovation Facility and discover the future of AI! (21 May) MAI24TourDIF.eventbrite.co.uk @DIF_Liverpool

English


